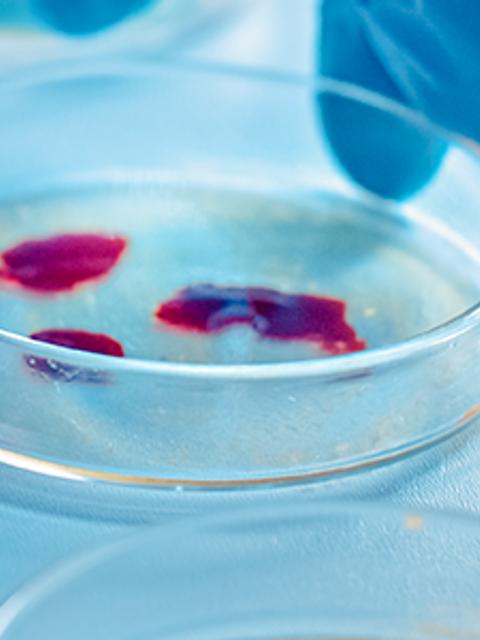
VI Simposio de Valoración y Conservación de los Recursos Microbianos

VI Simposio de Valoración y Conservación de los Recursos Microbianos
- ¿Cuándo?11 y 12 de septiembre 2024
Los recursos genéticos microbianos son esenciales para desarrollar soluciones biotecnológicas que nos ayuden a enfrentar algunos de los grandes desafíos que tenemos como humanidad: cambio climático, incremento en la demanda de alimentos, energías renovables, biorremediación de ambientes, entre otros.
Las colecciones de cultivos son instituciones que se dedican a preservar de manera ex situ el material microbiano de diversos ambientes, garantizando su pureza y viabilidad por períodos de tiempo prolongados. Además, proporcionan recursos útiles para la estandarización de métodos y validación de productos para investigación multisectorial.
De esta manera, nace en el 2019, la primera versión del Simposio Chileno de Conservación de los Recursos Microbianos y que, a la fecha, se ha ido posicionando como un gran evento de divulgación científica con enfoque en la internacionalización, gracias a la colaboración de trabajos científicos de investigadores nacionales e internacionales como a los expositores que cada año participan.
OBJETIVOS
Objetivo General
Reunir a la comunidad académica, científica y al público en general de Chile y América Latina, para concientizar sobre la importancia de la conservación de los recursos microbianos y las diferentes aplicaciones que estos recursos nos ofrecen.
Objetivos Específicos
- Coordinar la realización ponencias de expertos nacionales e internacionales en áreas afines al simposio.
- Dar a conocer trabajos científicos de estudiantes de pre y postgrado y de investigadores latinoamericanos en el ámbito de la valoración de recursos genéticos microbianos.
Público Objetivo
- Estudiantes de pre y posgrado.
- Académicos.
- Investigadores.
- Personas relacionadas al sector productivo.
EQUIPO ORGANIZADOR
- Dra. Sara Cuadros: Académica e investigadora de la escuela de Ingeniería en Biotecnología UCM
- Dr. Jean Franco Castro: Curador Banco de Recursos Genéticos Microbianos. INIA QUILAMAPU (Chillán)
Sexta Edición
La Universidad Católica del Maule y el Instituto de Investigaciones Agropecuarias (INIA) Quilamapu, tienen el agrado de invitarlos a la sexta versión del Simposio de Valoración y Conservación de los Recursos Microbianos a realizarse en modalidad híbrida entre el 11 y 12 septiembre de 2024 (09:30 AM-13:30 PM hora de Chile continental) mediante transmisión en vivo por el canal de YouTube de la UCM.
ENVÍO DE RESÚMENES
Esta edición del Simposio tendrá un enfoque en trabajos de estudiantes e investigadores tanto nacionales como internacionales en el ámbito de las Biomoléculas: metabolitos y enzimas de origen microbiano y sus aplicaciones.
Envíanos un resumen de tu trabajo científico para ser considerado dentro de las ponencias del evento; el formato de resumen está disponible en el enlace inferior.
*El plazo para el envío de resúmenes es hasta el 28 de junio 2024.
Inscripciones
Para registrarte en el evento, completa el siguiente formulario de inscripción para participar como asistente.